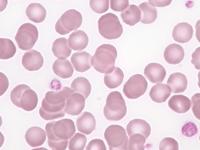
血小板减少症

吃什么治血小板减少症
分享者:三棱
更新时间:2016-11-19 16:32:26
229阅读
- 概述
-
血小板减少治疗方法有哪些?血小板减少吃什么好?马上跟随医通无忧网来详细了解一下吧!
- 吃什么治血小板减少症
-
1、龙眼枣米粥 取花生米、大枣各30克、龙眼肉10克,粳米50克。同煮粥食用。

-
2、鳖肉脊髓汤 用鳖肉250克,猪脊髓200克,葱3克,姜1克。鳖肉、葱、姜少许煮熟后,再加入脑脊髓。煮20分钟后,加入食盐、酱油调味食用。推荐阅读:治疗血小板减少症民间偏方

-
3、牛肉鹌鹑汤 取鹌鹑(去毛及肠杂,洗净)1只、牛肉250克、小麦50克。鹌鹑、牛肉、小麦同煮,加入少量食盐调味,即可食用。

- 注意事项
-
由于血小板减少性紫癜,一旦发病病情就比较危急,而且对患者的身体损害严重性也比较大。所以,为了患者的身体健康考虑必须要卧床休息,还要特别注意避免创伤,以免疲劳加重病情。
温馨提示:以上经验分享由网友原创分享,仅供参考,未经许可禁止转载,违者必究
相关图片
热门资讯
还有疑问?可免费咨询医生为你解答
最新经验
more+
- 漂亮的姑娘刚刚分享了经验 “ 轻型地中海贫血有哪些... ” 2018-01-15
- 花女人刚刚分享了经验 “ 一个月大的小孩贫血会... ” 2017-12-18
- 天有情刚刚分享了经验 “ 十一月婴贫血什么症状 ” 2017-12-13
- 专属权刚刚分享了经验 “ 静止型地贫有什么症状 ” 2017-12-05
- 画皮刚刚分享了经验 “ 宝宝先天性贫血是什么... ” 2017-12-01